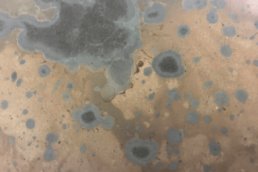

Make the Most of Metalier
Creating with multi-metals is one way to use the benefits of Metalier’s liquid metal to best advantage. We’ve never heard of sheet metal, for example, being able to layer patterns and textures or to use multi-metals at all.
Opening the Door to More Possibilities
Don’t get us wrong though – sheet metals are amazing at what they do best, and we are amazing at what we do best. And what we do best is different. We excel when corners or curves are involved. We also excel when you want to create an effect using one or two or even more metals. After all – why use only one metal when you could use two, three or even more?
So multi-metals might mean that you create a pattern using two metals in our range. The MM2 classic gold and black copper snakeskin pattern is created with a black copper base, gold overtones and then finished with patina. MM5 Gunmetal Bronze and Bronze are used together to create an interesting mottled effect. So, in these examples, the separate metals are kept separate.
Multi-Metals Finishes
Make It Your Own with Multi-Metals
In the central design featured on this page every layer of the finish is a multi-metal performance. The background colour is a combination of metals and so is the top coat. And after the combination of metals is the pattern and the skills and dedication to create the overall effect.
In addition to using several or many metals together, patination – or the use of patinas, is another way of enhancing your metal surface. Patina creates another whole level of interest, design and nature. Metalier prides itself on its understanding and use of patinas to create unusual and striking effects.
Black wax is also used to give depth to textured finishes and to add interest. See the PT12 classic gold moonrock with black wax.
There is no limit to what can be achieved using Metalier liquid metal for multi-metal effects, patterns, waxes and patination.
Learn how Metalier Coatings can help you to create something different: